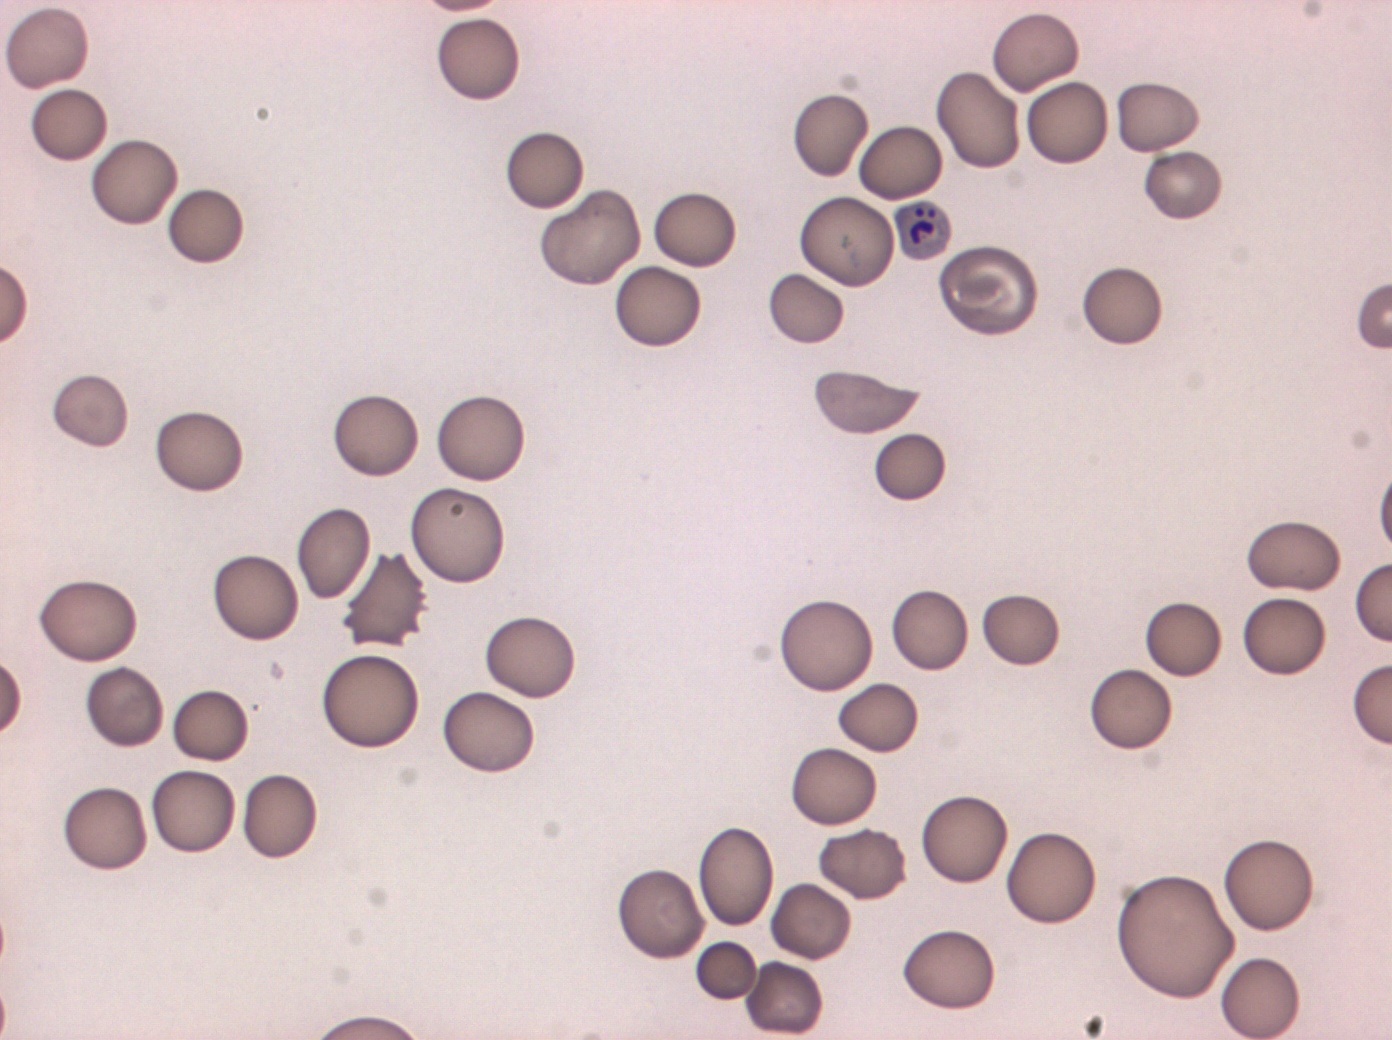

Склеенные эритроциты
Склеенные эритроциты 103 фотографий
26 в 25 степени
Животные в жигулевском заповеднике
Спирально шовные трубы
Наперечет это
Ветер уровень в москве
Лодка днепр технические характеристики
Лесной цветок сиреневого цвета
Что делать если синие руки
Операция конский хвост
Стеллажи для прутков